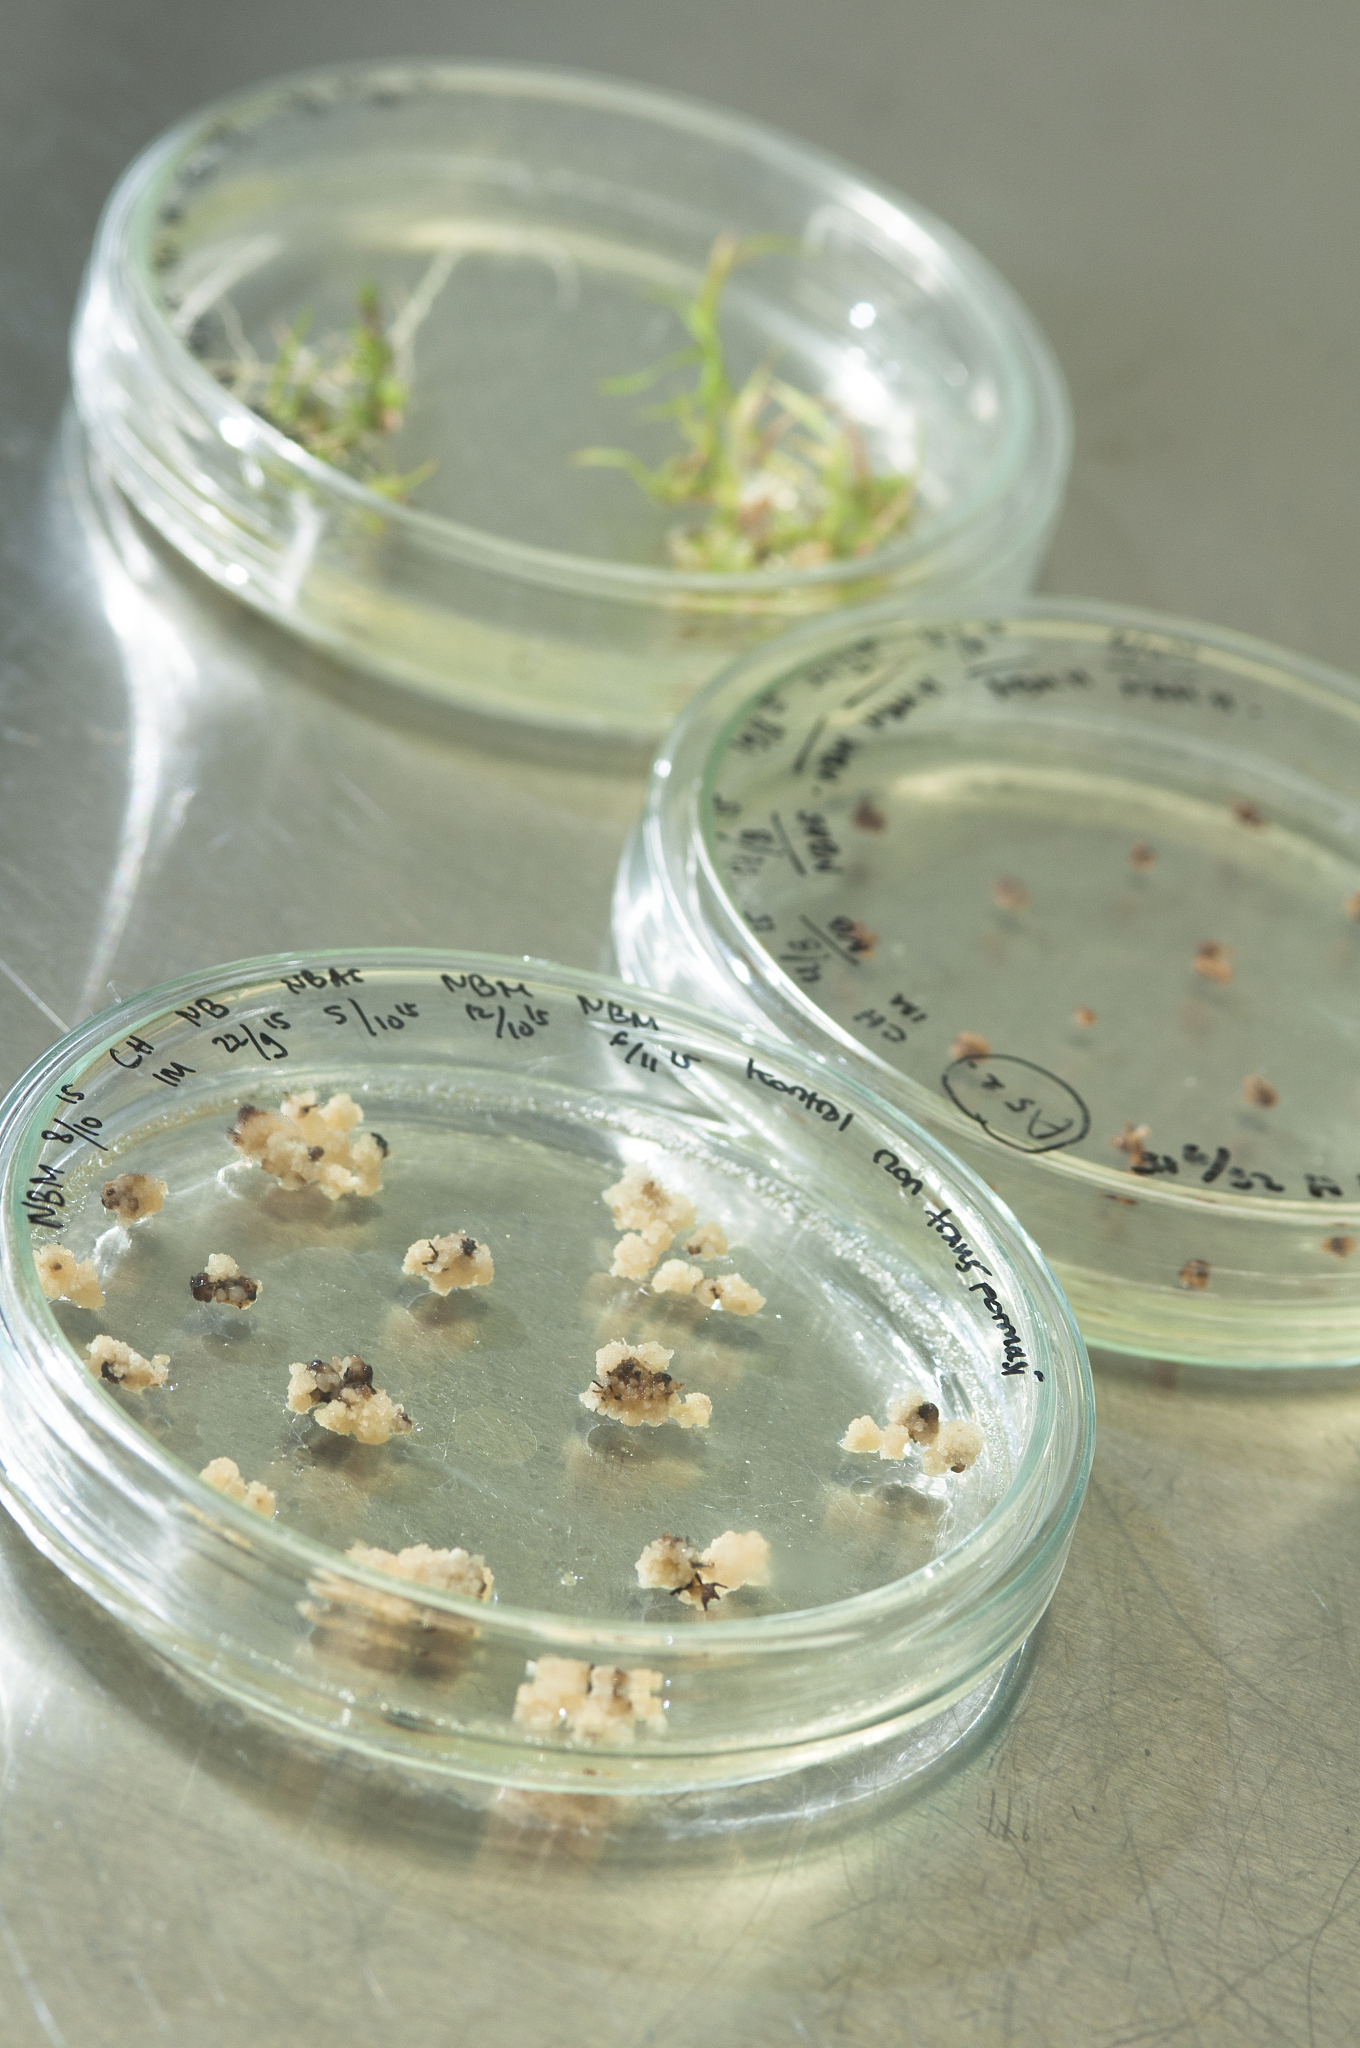
西测测试：公司环境可靠性试验中的霉菌试验、盐雾以及电磁兼容均可以为海工装备提供相

-
面向性激素居家监测的亚飞摩尔级柔性传感电极
生物分子的实时检测对于体外诊断、疾病早期检测以及日常健康监测和管理至关重要。类固醇性激素如孕酮(P4)、雌二醇(E2)和睾酮等,虽然在体内浓度极低(
02.07 -
恶魔、反叛者与盲盒之神:Labubu在北美的文化符号转生
在美国加州圣荷西郊外的山道上,一位74岁的墨西哥裔老人正在晨练。他腰间别着一只浅绿色的马卡龙系列Labubu,这个玩具的名字叫“青提莓莓”,是他最喜
02.07 -
飞行汽车霉菌试验箱
飞行汽车霉菌试验箱可用于电动垂直起降飞行器、eVTOL飞行器、无人机等低空经济领域中的霉菌试验,通过霉菌试验可验证设备及其材料的抗霉能力,有利于指导
02.07 -
Nature系列综述:谭蔚泓院士解读改写医学未来的功能性核酸——适配体、脱氧核酶
在传统认知中,核酸(DNA 和 RNA)只是遗传信息的载体。实际上,单链核酸可通过碱基互
02.07 -
低空载人飞行器霉菌实验箱对飞行汽车样品的试验研究
低空载人飞行器工作在潮湿和湿热环境中,有适宜霉菌生长的温度和湿度(一般温度24~31℃,湿度达到70%),霉菌的孢子就会在机体表面萌芽和生长,造成机
02.07 -
淮北师大学生团队研发新型水凝胶传感器 实现血清中过氧化氢酶高灵敏检测
近日,淮北师范大学物理与电子信息学院朱佳伟指导的学生团队在中科分一区TOP期刊《Chem
02.07 -
西测测试:公司环境可靠性试验中的霉菌试验、盐雾以及电磁兼容均可以为海工装备提供相
同花顺300033)金融研究中心07月14日讯,有投资者向西测测试301306)提问, 你好董秘,据悉公司于近期中标中国船舶下属公司相关检测业务,请问贵
02.07 -
无锡源清天木生物科技申请检测谷氨酰胺的酶膜传感器制备方法专利适合于谷氨酰胺在线监
铂热电阻(Pt100/Pt1000)温度采集模块凭借高精度、高稳定性、抗干扰性强的特性,成为实验室温度测量与数据采集的核心设备,适配物理、化学、生物、材
02.07